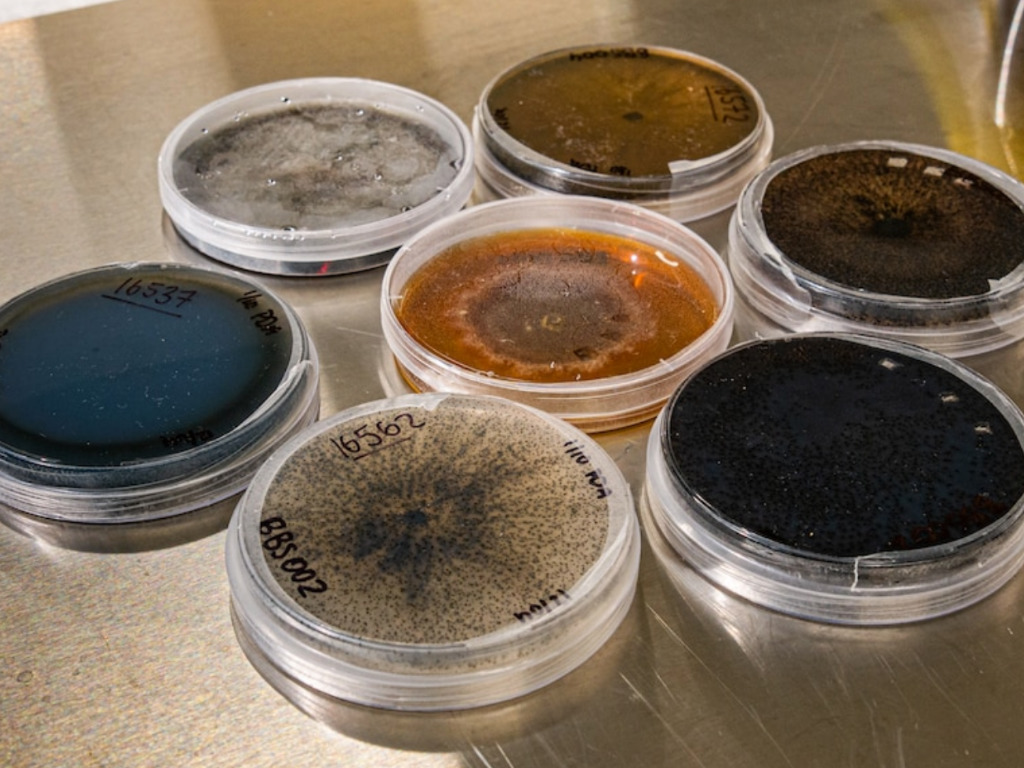

4 Mins Read
Soil Carbon is developing a technology to capture carbon from the air and if microbes can be a potential solution to store this stable carbon in the soil. This will in turn improve soil health and open ways for farmers to begin trading carbon offsets.
In an effort to reduce the CO2 present in the atmosphere and to increase carbon capture in our soils, NSW-based Soil Carbon is exploring if a fungi called dark septate endophytes can be the solution to these problems.
How Does It Work?
Co-founded by agronomist Guy Webb and Tegan Nock in 2019, the company aims to arrive at a solution which helps farmers in the the fight against climate change. The team of scientists along with Nock have looked through a library of 1,500 microbes to find which ones will be ideal for sequestering carbon.
Through a fungal treatment, or inoculum the microbes are applied to the crop seeds. In the form of stable sugars, carbon builds up around the roots of the plants. This process builds carbons that can remain in the soil for hundreds or thousands of years.
In an interview with ABC, Webb said: “It’s always a battle for farmers to maintain soil carbon and over the whole cropping belt worldwide we’ve lost about 60% of our soil organic carbon out of our cropping soils. If we can draw carbon out of the atmosphere, and trap it in the soil, which increases soil health, we’re doing something about climate change mitigation at the same time.”
Read: Carbon Capture Is Distracting From The Critical Need To Cut Emissions, Experts Warn
Chief product officer Nock said that the product was a tool which will support the agricultural industry in meeting carbon targets in the future. “It’s something that’s really heartening to see in terms of that effect to be able to not just increase carbon that’s tradable, but really stable carbon to give that certainty on that trade.”
Status Of Trials
The field trials have been successful, with an average 7% yield increase and 2.6-tonne increase in tradable carbon per hectare.
It’s always a battle for farmers to maintain soil carbon and over the whole cropping belt worldwide we’ve lost about 60% of our soil organic carbon out of our cropping soils
Guy Webb, co-founder of Soil Carbon
Soil carbon researcher of the NSW Department of Primary Industries, Susan Orgill said that there is huge potential in carbon sequestering biotechnologies, even from governments. For instance, under the Emissions Reduction Fund, soil carbon projects constitute 14% of the total projects. “It’s a really exciting and promising part of our soil carbon science. We know that in low disturbance agriculture, while fungi might only be say 10% of the total microbial biomass, they’re responsible for between 35 and 75% of all carbon that’s sequestered.”

According to a report, demand for carbon credits will is set to increase by a factor of 15 by 2030, with the market possibly worth $50 billion.
In low disturbance agriculture, while fungi might only be say 10% of the total microbial biomass, they’re responsible for between 35 and 75% of all carbon that’s sequestered
Susan Orgill, soil carbon researcher of the NSW Department of Primary Industries
Government Support
The startup which has has received $10 million in private and government funding, has the further backing of the federal government given that it has pledged US$200 million to the National Soil Strategy. This particular scheme pays rebates to farmers who share data on soil. It even invests in slashing the price of soil carbon measuring by 90%.
Read: Regenerative Agriculture: U.S. Farmer Sequesters Carbon For Cash Earning US$115,000
Webb concluded by saying that if the financial perks of carbon farming is increased, it will not only get more farmers and producers on the trading market, but also be an effective way to mitigate climate chnage.
Lead image courtesy of Soil Carbon.




